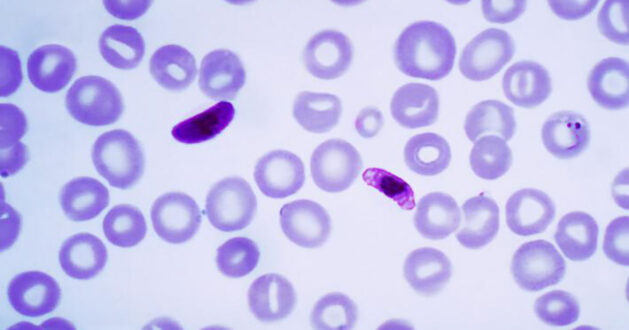

8 Ocak 2023
Sıtmaya karşı üç dozluk tam parazit aşı rejiminin [Plasmodium falciparum sporozoite (PfSPZ) aşısı] endemik bölge Batı Afrika, Burkina Faso’da yaşayan yetişkinlerde güvenli ve etkili olduğu gösterildi. Bulgular 7 Aralık 2022’de Science Translational Medicine’de yayımlandı. Çalışmaya Maryland Üniversitesi, Tıp Fakültesi’nden Aşı Geliştirme ve Küresel Sağlık (CVD) Merkezi araştırmacıları öncülük etti.
2020 yılında dünya çapında yaklaşık 241 milyon kişiye sıtma bulaştı ve 627 000 kişi sıtma nedeniyle yaşamını yitirdi. Bilim adamları onlarca yıldır etkili bir sıtma aşısı geliştirmek için uğraşmakla birlikte pek başarılı olamadılar. Bunun nedeni, hayatlarının erken dönemlerinde sıtmaya yakalanmış kişilerde kazanılmış bağışıklıkları nedeniyle aşıların fazla koruma sağlamadığının gösterilmesidir. Sıtmaya karşı ilk aşı (RTS,S/AS01) Ekim 2021’de Dünya Sağlık Örgütü tarafından onaylandı ve sıtmaya karşı mütevazı bir koruma sağlıyor.
PfSPZ, daha önce sıtma ge.iren Afrikalı yetişkinlerde doğal olarak bulaşan sıtma infeksiyonuna karşı %52 aşı etkinliği sağladı; koruma 8-14 ay sürdü.